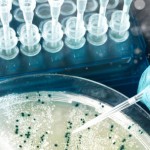

Chaque semaine, Maddyness reprend dans sa revue de presse l’actualité startups qui a retenu l’attention de la rédaction dans la presse. Si vous n’avez rien suivi de la semaine, pas de panique, tous les éléments importants sont sur Maddyness et dans la revue de presse.[hr]
![]() |
Santé : 10 start-up qui vont révolutionner le secteurSelon une étude de Xerfi-Precepta, le marché mondial de l'e-santé, qui a pesé 2,4 milliards d'euros en 2012, devrait progresser de 4% à 7% en moyenne par an, à l'horizon 2017. Sélection de 10 start-up qui surfent sur ce secteur porteur. (Journal du Net) |
![]() |
Quand les startups transforment nos assiettesDe Bill Gates à Sergey Brin, en passant par Peter Thiel, Biz Stone ou encore Evan Williams. Les grand noms de la high-tech américaine se bousculent pour investir dans des startups partant à l’assaut du secteur agro-alimentaire. Ces derniers mois, leur nombre n’a cessé de progresser. Elles attirent l’attention des médias, suscitent aussi le scepticisme, voire l’inquiétude. (L'Atelier) |
![]() |
L'e-commerce de l'art a le vent en poupeLe marché de l'art en ligne connaît une croissance insolente. D'ici cinq ans, il devrait plus que doubler en valeur, pour atteindre 3,76 milliards de dollars, contre 1,57 milliard en 2013, selon le dernier rapport Hiscox/ArtTactic, publié fin avril. (La Tribune) |
![]() |
FrenchTech : faisons un rêve à 15 millions d'eurosIl y a quelques semaines, j'étais à San Francisco et j'ai pu y rencontrer quelques entrepreneurs français. J'ai été surpris de constater à quel point, pour beaucoup d'entre eux, ils avaient "rompu" avec la France. Une rupture dont la principale expression est tout simplement l'indifférence. Mais une indifférence teintée d'un peu de compassion, voire de condescendance pour ceux (les entrepreneurs) qui sont restés là-bas malgré tout. (Huffington Post) |
![]() |
Yahoo est-il un fossoyeur de start-ups ?Depuis son arrivée à la tête de Yahoo, en juillet 2012, Marissa Mayer a donné le coup d'envoi d'une course à l'acquisition. De trois rachats en 2011 et deux en 2012, Yahoo est passé à 27 en 2013. Et depuis le début de l'année, le géant a déjà mis la main sur huit sociétés. De toutes les start-up acquises, combien ont simplement vu leur produit disparaître ? Gare aux "acqui-hires"... (Journal du Net) |
N’hésitez pas à nous communiquer d’autres articles intéressants qui auraient pu échapper à notre veille, les commentaires sont là pour ça! Vous voulez suivre notre veille au jour le jour? Vous pouvez la retrouver sur notre scoop.it et notre compte Twitter.
Crédit photo : Shutterstock